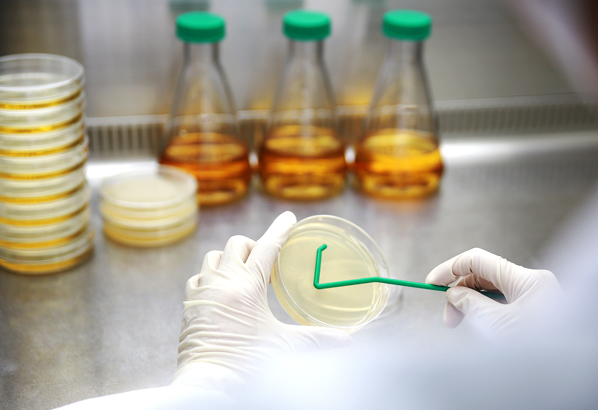
SPL Spreader 推刮器, PP, Sterile to SAL 10-6 90050 - 商品圖 2

商品圖片僅供參考,選購時請再留意商品規格
商品圖片僅供參考,選購時請再留意商品規格
現貨商品
SPL
SPL Spreader 推刮器, PP, Sterile to SAL 10-6 90050
商品包含多種型號及規格,請點選「立即選購規格」挑選
💡 重要通知:
因中東戰爭造成原物料波動影響,若訂單成立後進貨成本發生重大異動,我們將主動聯繫您協商處理。造成不便,敬請見諒。
月結報帳 / 信用卡 / 銀行轉帳
宅配快速到貨,滿 NT$ 999 元即享免運!
選購型號
商品介紹
以上圖片及相關資訊由 SPL提供。
若有現場安裝、說明或特殊配送需求,歡迎事前與科研市集聯繫。部分商品因供應條件限制,可能無法提供相關服務,敬請見諒。









